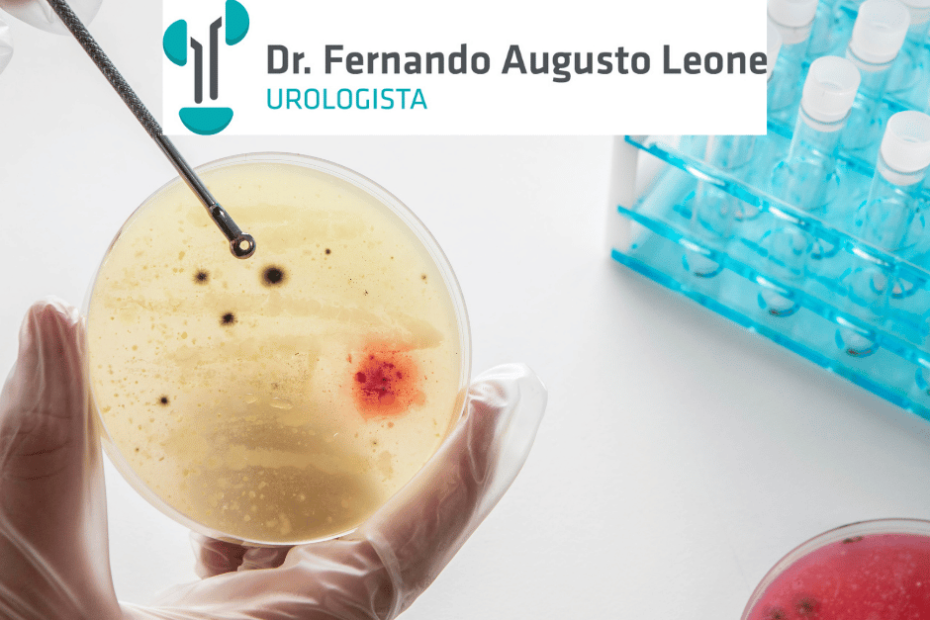

Uretrite gonocócica
A uretrite gonocócica é uma infecção sexualmente transmissível que provoca inflamação da uretra, geralmente causada pela bactéria Neisseria gonorrhoeae. A condição pode afetar homens e mulheres, com manifestações distintas, mas igualmente importantes. Identificar os sinais precocemente e buscar atendimento médico é fundamental para evitar complicações mais graves.
Sintomas mais comuns da uretrite gonocócica
Nos homens, a uretrite gonocócica costuma se manifestar por um corrimento uretral purulento, de coloração amarelada ou esverdeada, associado a dor ou ardência ao urinar. Pode haver também coceira na região genital e aumento da frequência urinária.
Nas mulheres, os sintomas podem ser mais discretos. Corrimento vaginal, dor pélvica, desconforto ao urinar e sangramentos fora do período menstrual podem ocorrer. Devido à menor especificidade dos sintomas, muitas mulheres só descobrem a infecção durante exames de rotina.
Como é feito o diagnóstico da uretrite gonocócica
O diagnóstico clínico é baseado nos sintomas e no exame físico. Em alguns casos, pode ser necessário realizar testes laboratoriais para confirmar a presença da bactéria causadora da uretrite gonocócica. A coleta de secreção uretral ou vaginal e exames específicos permitem identificar a infecção com precisão.
Tratamento da uretrite gonocócica: qual o mais indicado?
O tratamento da uretrite gonocócica é feito com antibióticos, geralmente em dose única. A combinação de medicamentos injetáveis com antibióticos orais é a abordagem mais comum, visando eliminar completamente a bactéria e reduzir o risco de transmissão.
É essencial que os parceiros sexuais também sejam tratados, mesmo que não apresentem sintomas. Essa medida evita reinfecções e contribui para o controle da propagação da doença.
Riscos e complicações da uretrite gonocócica
Quando não tratada adequadamente, a doença pode evoluir para quadros mais graves, como infecção dos testículos, próstata ou útero. Além disso, há risco aumentado de infertilidade e disseminação da bactéria para outras partes do corpo. A infecção também aumenta a suscetibilidade a outras doenças sexualmente transmissíveis.
Como prevenir a uretrite gonocócica
A prevenção passa pelo uso correto e regular de preservativos durante as relações sexuais. A realização de exames periódicos, especialmente em pessoas com múltiplos parceiros, é fundamental. A educação sexual e a comunicação entre parceiros também desempenham um papel importante na prevenção.
É possível consultar pelo plano de saúde?
sim, realizo atendimentos e cirurgias por diversos planos de saúde assim, como pelo saúde Bradesco, Amil, Sulamerica.
É possível realizar cirurgias pelo plano de saúde?
Sim, conseguimos realizar algumas cirurgias pela maioria dos planos de saúde.
Cirurgias nos principais hospitais de BH ( Mater Dei Bh, Vila da Serra, Uromaster) e clínica de urologia BH.
Procure sempre seu urologista, e mantenha seus exames em dia. Urologista BH, Uro BH, urologista em Nova Serrana, Urologista em Pará de Minas, Urologista Pitangui.
Gostou do artigo? Ainda tem dúvidas? acesse meu blog onde tenho outros artigos relacionados: